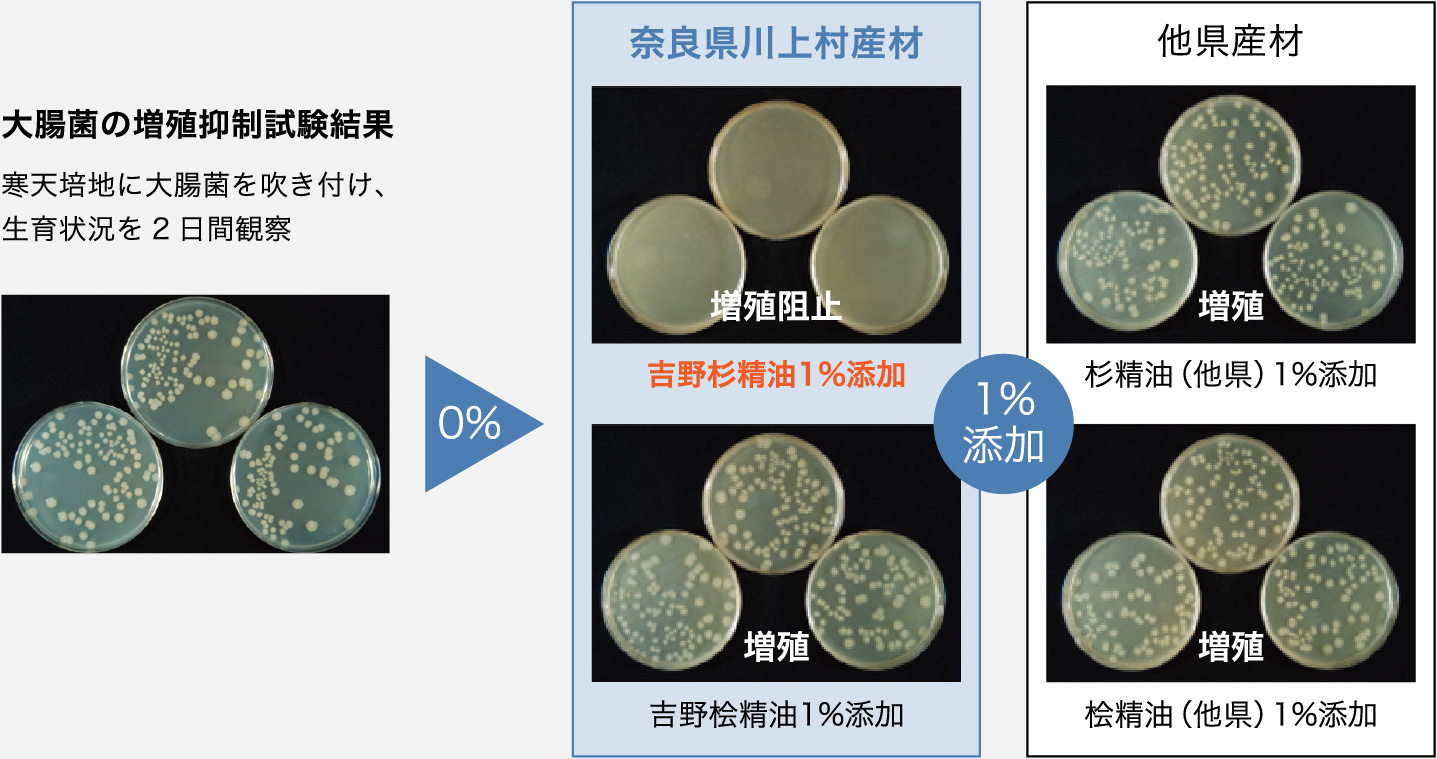

川上村産吉野杉と木口スリット加工、Wの効果で心と身体が健やかに!
川上村産吉野杉の効果
〈抗菌効果〉 川上村産吉野杉は菌が増えにくい!
川上村産吉野杉の精油は、1%の添加で大腸菌の増殖を阻止しました。杉材(心材)には精油が1〜2%含まれているため、[吉野杉 木口スリットパネル]に抗菌効果が期待できます。
出典:奈良県 奈良の木ブランド課 平成28年度 奈良の木で健康になる実証事業&平成29年度奈良の木で快適に暮らす検証事業、奈良の木で健康・快適に暮らす!!ハンドブック(平成30年9月発行)
〈防カビ効果〉 川上村産吉野杉はカビが生えにくい!
川上村産吉野杉の精油は、5%の添加でカビの生育をほぼ阻止しました。[吉野杉 木口スリットパネル]にを使用すれば、カビによるアレルギー疾患(喘息、アトピー性皮膚炎など)が起こりにくくなる可能性があります。
出典:奈良県 奈良の木ブランド課 平成28年度 奈良の木で健康になる実証事業&平成29年度奈良の木で快適に暮らす検証事業、奈良の木で健康・快適に暮らす!!ハンドブック(平成30年9月発行)

吉野かわかみ社中も参加した、奈良県の「平成28年度 奈良の木で健康になる実証事業&平成29年度奈良の木で快適に暮らす検証事業」において、人にやさしい吉野杉の数々の効用が証明されました。
〈試験材料〉
- ・川上村産吉野杉 100年生及び70年生※(板、木粉、精油に調整)、川上村産吉野桧 100年生及び70年生※(板、木粉、精油に調整)
-
・比較のための材料 他県産スギ材30~40年生、他県産ヒノキ材30~40年生、他県産スギ精油(市販品)、他県産ヒノキ精油(市販品)
※奈良県産材は、樹齢70年以上が主流であるため、他県産材とは異なる樹齢で試験をしています(丸太の直径はほぼ同じ) - ・比較のために用いた木材以外の材料 カーペット生地(ポリエチレン)、プラスチック(塩化ビニル等)、金属(アルミニウム等)
木口スリット加工の効果
〈空気の浄化効果〉 空気をきれいにして脳と身体を活性化
[吉野杉 木口スリットパネル]は、二酸化窒素やホルムアルデヒドなど空気中の有害物質を吸着し、空気をきれいにする効果があります。脳の活性化をサポートし、身体全体を活き活きさせます。
出典 : 辻野善夫、中戸靖子、畑瀬繁和、根来好孝、川井秀一、三宅英隆、藤田佐枝子:スギ木口スリット材の大気浄化性能、 平成21年度大阪府立環境農林水産総合研究所研究発表会要旨集、成果集(環境分野)(2009)


〈気分を集中&リラックス効果〉 心と身体を落ち着かせる
[吉野杉 木口スリットパネル]を内装に用いた部屋の見た目は、白色塗装の無機質な部屋や一般的な杉板材(板目材)に比べ生理的に落ち着く空間であることが分かりました。また、その香りにおいても、リラックス効果をもたらすことが検証されています。
出典 : 木村彰孝、仲村匡司、藤田佐枝子、川井秀一: スリット加工が施されたスギ材の観察がヒトに及ぼす影響Ⅰ自律神経活動および気分・感情の変化について、第62回日本木材学会全国大会研究発表要旨集、CD-ROM (2012)

※この表は右にスクロールできます。

川上村産吉野杉が快適で健康的な暮らしを実現!
〈湿度調整効果〉 カビ、ダニ、ウイルスの増殖を抑え健康快適
吉野杉は他の木材同様に高い湿度調整機能を発揮。さらに[吉野杉 木口スリットパネル]は、室内の湿度を一定に保とうとする調湿作用が非常に高いことが分かりました。これによりカビ・ダニ・ウイルスなどの増殖を防ぎ、快適な室内環境をつくることができます。
[吉野杉 木口スリットパネル]の吸湿性
出典 : 奈良県森林技術センター センターだよりNo.128,20194
[吉野杉 木口スリットパネル]の吸湿性
出典 :中川美幸、木村彰孝、中山雅文、藤田佐枝子、梅村研二、川井秀一: 保存空間に施工したスギスリット材の調湿効果、第62回日本木材学会全国大会研究発表要旨集、CD-ROM (2012)


〈免疫力アップ効果〉 身体の抵抗力を高め病気になりにくい体に
杉材の机・椅子を使用した学校の調査では、杉材から発散される揮発成分により消化管や呼吸器の免疫機構「免疫グロブリンA」の分泌を促進し、30%増加することが確認されました。「免疫グロブリンA」が増加すると、自然免疫力が強化され、喉や鼻などの粘膜を細菌ウイルスから守る力が高まり風邪やインフルエンザの予防にも役立つと考えられています。
〈臭気低減効果〉
川上村産吉野杉が臭気(におい)を低減!
密閉性の袋に試験材料と臭気ガス(アンモニア)を入れ、袋中のガス濃度を一定時間ごとに測定したところ、[吉野杉 木口スリットパネル]は10分で9割以上の臭いを除去しました。

〈ウイルス抑制効果〉
川上村産吉野杉でウイルス感染力が低下!
杉、桧の木粉と比較のためポリプロピレンの粉および鉄粉を使用。これらの材料にウイルス液(インフルエンザA型)を接触させた後、感染力を測定しました。結果、70年生の吉野杉は桧と同等の感染力低減効果を発揮しました。

納材事例
「吉野杉 木口スリットパネル」
その他の情報













